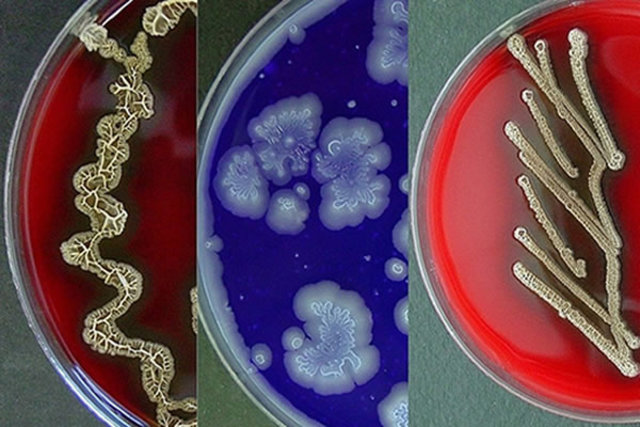
Comceptos de diversidad  de morfologias  poliomielitis

-
Girolamo Fracastoro. Médico, científico, escritor y poeta italiano. Sus observaciones sobre la naturaleza y la propagación de las enfermedades infecciosas le convierten en el padre de la epidemiología científica, que consiste en el estudio de la incidencia de las enfermedades y de los factores ambientales que influyen en su transmisión.
-
Robert Hooke publica , una colección de micrografías biológicas. Descubre unas estructuras en la corteza de un corcho a las que llama células.
-
-
Redi, Francesco
-
-
Segundo periodo, de lenta acumulación de observaciones (desde l675 aproximadamente hasta la mitad del siglo XIX), que arranca con el descubrimiento de los microorganismos por Leeuwenhoek
-
-
-
inevestigado por Von Plencizk
-
Edward Jenner
-
Friederich Miescher
-
La teoría microbiana de la enfermedad o teoría germinal de las enfermedades infecciosas es una teoría científica que propone que los microorganismos (son la causa de una amplia gama de enfermedades. Estos pequeños organismos, casi todos demasiado pequeños para verlos a ojo desnudo, invaden a los humanos, animales y otros huéspedes vivos. Su crecimiento y reproducción dentro del portador puede producir una
-
-
-
Louis Pasteur
-
-
Paul Ehrlich
-
El proceso de producción de acetona y butanol por bacterias fue descubierto por Chaim Weizmann,a producción de acetona era esencial en el proceso de fabricación de las municiones, por lo que el descubrimiento de Weizmann jugó un papel determinante en el desarrollo de la guerra.
-
David Bergey, catedrático de bacteriología en la Universidad de Pennsylvania, y cuatro colaboradores más, publicaron un manual sobre características de las bacterias de interés médico conocidas hasta entonces, que podía utilizarse para la identificación bacteriana. Este manual, el Bergey's Manual of Determinative Bacteriology, ha sido utilizado en muchos laboratorios de Microbiología de todo el mundo y ha ido actualizándose a lo largo de los años hasta que apareció la novena y últim
-
Observacion de los primeros virus gracias a la invenciòn del microscopio
-
-
Escocia- inglaterra por Alexander peming,Ernts Chain y Howrad florey.
-
En todo el mundo, se emplean dos tipos de vacuna contra la poliomielitis. La primera fue desarrollada por Jonas Salk, probada por primera vez en 1952 y fue dada a conocer por Salk el 12 de abril de 1955. La vacuna Salk contra la poliomielitis consiste en una dosis inyectada de poliovirus inactivados o muertos. La segunda vacuna fue una vacuna oral desarrollada por Albert Sabin usando poliovirus atenuados. Los ensayos clínicos de la vacuna Sabin iniciaron en 1957 y fue autorizada en 1962.
-
-
Escherichia coli es la célula de vida libre, es decir ser viviente autónomo, de la que tal vez sepamos más al momento. Como dice Fred Neidhardt, reconocido microbiólogo, todo biólogo conoce al menos dos células, aunque no esté consciente, la que trabaja y E. coli. Esta frase anecdótica, refleja en mucho la forma de trabajo y anotación de los proyectos genómicos. El primer paso fundamental en un proyecto genómico es por supuesto secuenciar un genoma. El paso siguiente es hacer su anotación, que c
-
Encefalopatía Espongiforme bovina “vacas locas” Creutzfeldt-Jakob.
Se denominan Encefalopatías Espongiformes Transmisibles (EET) a un amplio grupo de enfermedades neurodegenerativas de los animales y del hombre, entre las cuales se encuentra la Encefalopatía Espongiforme Bovina (EEB; en inglés Bovine Spongiform Ence-phalopathy, BSE) o «mal de la vaca loca». -
Los investigadores estadounidenses Peter Agre y Roderick Mac Kinnon recibieron el Premio Nobel de Química por sus descubrimientos sobre la estructura proteica de los canales iónicos y del agua en la membrana celular.
Estas proteínas permiten el pasaje de sustancias imprescindibles para la vida celular y por consiguiente para el organismo. -
Las micobacterias son bacterias aerobias y no móviles (con excepción de la especie M. marinum, que ha mostrado ser móvil dentro de los macrófagos). Tienen ácido-alcohol resistencia,3 no producen endosporas ni cápsulas y suelen considerarse grampositivas. En algunos casos, estos bacilos pueden formar filamentos ramificados; sin embargo, estos pueden romperse con facilidad.
-
Se esta iniciando la última fase para la erradicación mundial de la infección natural por el virus de la polio.
-
Las micobacterias son bacterias aerobias y no móviles (con excepción de la especie M. marinum, que ha mostrado ser móvil dentro de los macrófagos). Tienen ácido-alcohol resistencia,3 no producen endosporas ni cápsulas y suelen considerarse grampositivas. En algunos casos, estos bacilos pueden formar filamentos ramificados; sin embargo, estos pueden romperse con facilidad.
Looking for a timeline maker?
Create timelines for projects, roadmaps, history, lessons, legal cases, and stories with Timetoast. Timetoast is a timeline maker for work, school, research, and stories.